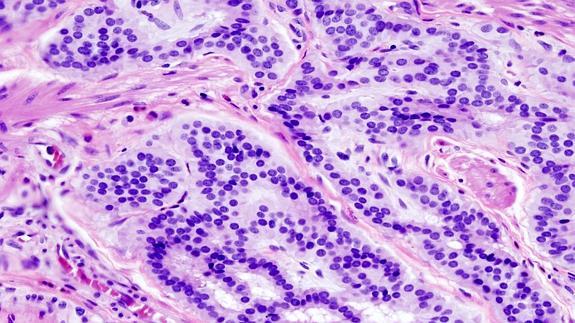
¿Cuál es el corte de rutina en histología?

Publicado enHistología
Uso del formaldehido en histología
El formaldehído, componente activo de la formalina, desempeña un papel fundamental en la fijación de muestras en histología y patología debido a su capacidad excepcional para preservar la estructura general…